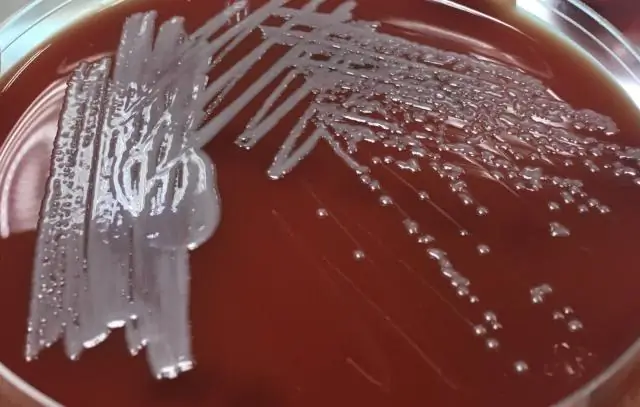
Микробиология: вопрос стоимости

Вопрос стоимости
Некоторые бактерии так плохо используют свою пищу, что другие микробы могут хорошо жить на их «метаболических отходах». Почему эта неэффективность? Не лучше ли выжимать всю энергию из еды? Ответ может быть просто: Слишком дорого! Если дымоход не тянет должным образом, остается много золы и обгоревших дров. Некоторые бактерии столь же неэффективны со своим топливом - например, так называемые нитрификаторы: они «сжигают» аммиак до нитрита. Однако он по-прежнему содержит так много энергии, что служит пищей для второй группы нитрификаторов: это превращает его в конечный нитрат продукта.
Пока не обнаружено ни одного микроорганизма, который непосредственно превращает аммиак в нитрат. Русский микробиолог Сергей Николаевич Виноградский признал это еще в 1890 году, но хорошего объяснения этому до сих пор нет.
Ян-Ульрих Крефт из Боннского университета вместе с Энграсией Костой и Хулио Пересом из Автономного университета Барселоны теперь думают, что нашли такое решение. Поскольку короткие метаболические пути могут представлять собой эволюционное преимущество, объясняет Крефт: «Прежде всего, каждый метаболический шаг в организмах катализируется определенным клеточным белком, ферментом. Однако клеточный механизм может синтезировать только определенное количество фермента на единицу. времени. Это необходимо для цепи реакции из пяти стадий. Бактерии производят пять ферментов, из которых десять стадий соответствуют десяти. Конечно, для этого клетке требуется больше времени: она производит меньше копий каждого фермента за то же время». Следствие: пропускная способность метаболической цепи снижается.
Есть проблема и с промежуточными продуктами - чем больше звеньев в цепи обмена веществ, тем больше отходов: промежуточные продукты могут вступать в реакцию с другими веществами в клетке или теряться каким-либо другим образом.«Промежуточные продукты вызывают затраты»
(Ян-Ульрих Крефт) Иногда они нарушают регулируемые процессы в клетке и оказывают токсическое действие. «Промежуточные продукты вызывают затраты», - подчеркивает Крефт. «Поэтому бактерия будет стараться поддерживать свою общую концентрацию на как можно более низком уровне - чем длиннее цепь, тем ниже концентрация отдельных промежуточных продуктов».
Это дополнительно снижает пропускную способность. Вывод Крефта: «Дополнительный шаг имеет смысл только в том случае, если из него выпрыгивает много дополнительной энергии. Преобразование нитрита в нитрат просто не приносит достаточно усилий». Поэтому нитрификаторы, разделяющие работу, растут быстрее, чем «полные пищеварители», и обычно преобладают, даже если они такие плохие пищеварители.
Когда пища является дефицитным товаром, бактерии не могут позволить себе такую роскошь. Так обстоит дело, например, с биопленками - бактериальными покрытиями, такими как те, что встречаются на камнях в реках или на очистных сооружениях. Микробы в таких слоях относительно неподвижны; кроме того, запасы пищи ограничены, особенно в более глубоких районах. Если бактерия теперь использует пищу не полностью, чтобы иметь возможность расти быстрее, она перерабатывает большее количество пищи менее эффективно, из-за чего концентрация питательных веществ в ее среде снижается больше: ее соседи - которые вышли из нее путем деления - и она сама грозит этим голодом.
"Экономические бактерии", которые растут медленнее из-за более длинных метаболических путей, но более эффективно используют ресурсы, оставляют больше своим соседям. Таким образом, в биопленках полные пищеварители должны иметь избирательное преимущество, поскольку они извлекают из пищи все до последней крупицы энергии. «Чтобы найти бактерии, которые катализируют весь путь от аммиака до нитрата, вам, вероятно, придется искать биопленки», - говорит Крефт.
Микроб Holophaga foetida показывает, что ученые могут быть правы.«Вонючий полный переработчик», как его называют по-немецки, использует кольцеобразные углеродные соединения и использует для этого относительно длинный метаболический путь. Холофага медленно растет и в основном встречается в отложениях, где она, вероятно, обитает в биопленках. У него есть два конкурента, которые используют один и тот же процесс в два этапа. Они размножаются быстрее, чем голофаги, но все же встречаются реже - возможно, из-за более плохой конверсии корма. © Боннский университет